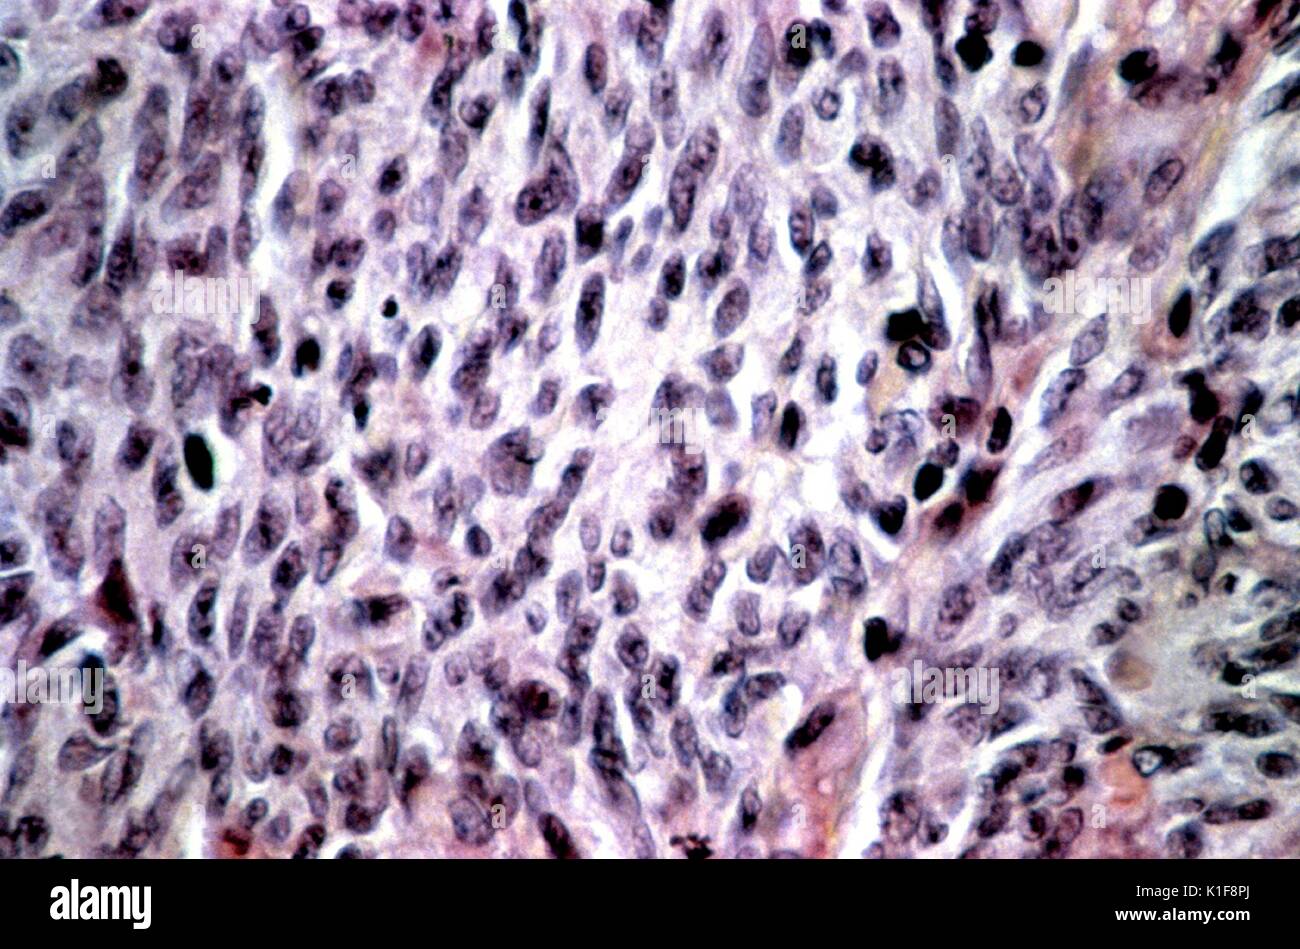

Саркома капоши у фредди
Цепочки золотые 70 см
Стал капризный ребенок 4 месяца
Еаэс образован
Идея юбилея 30 лет
Видео с самым большим просмотром на ютубе
Академик пивоваров википедия
Помощь деньгами от богатых на карту срочно
Игра футбол зенит краснодар
Курс злотого в калининграде энерготрансбанк
Поздравление стилягам
Прожектор 30 w
Шарики 2 головоломки
Новый корпус мгу
Саркома капоши у фредди 134 фотографий